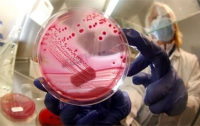
Элементарные правила пищевой безопасности летом

ВСЕ НОВОСТИ
-
 14:02 Общество
14:02 Общество
В Украине стало меньше некачественного мяса
-
 09:00 Общество
09:00 Общество
Как выбрать вкусную дыню
Поздние сорта этой бахчевой культуры более вкусные и полезные
-
 16:29 Мир
16:29 Мир
Еда в мире дешевеет, - Всемирный банк
-
 16:54 Здоровье
16:54 Здоровье
Продукты, пораженные грибками, повышают риск рака
-
 09:00 Общество
09:00 Общество
В киевских супермаркетах опасно покупать детское питание
Соблюдение температурного режима не выдерживает никакой критики
-
 13:49 Экономика
13:49 Экономика
В Крыму упали цены на 18 наименований продуктов питания
-
 07:45 Общество
07:45 Общество
В 2014 году украинские продукты станут более качественными, - эксперт
Это станет возможным, если Украина подпишет договор об ассоциации с ЕС
-
 10:19 Здоровье
10:19 Здоровье
Ученые обнаружили новый суперпродукт
Он не только содержит массу полезных веществ, но и обладает профилактическим эффектом
-
08:45 Общество
08:45 Общество
Элементарные правила пищевой безопасности летом
-
 12:53 Мир
12:53 Мир
В Великобритании будут штрафовать за выброшенную пищу
-
 08:01 Общество
08:01 Общество
Украинцам продают «гламурную» колбасу
-
 07:45 Общество
07:45 Общество
Предупреждения на украинских производителей не действуют
-
 22:00 Общество
22:00 Общество
Россияне не докладывают мяса в пельмени больше, чем украинцы
-
 11:35 Экономика
11:35 Экономика
Контролирующие качество пищевых продуктов службы нельзя сокращать, - мнение
Александр Бородыня полагает, что необходимо просто разграничить их полномочия
-
 11:10 Общество
11:10 Общество
Ответственность за то, что мы едим, мы несем сами, - СЭС
Александр Кравчук уверен, что государство в современном мире не может контролировать все




